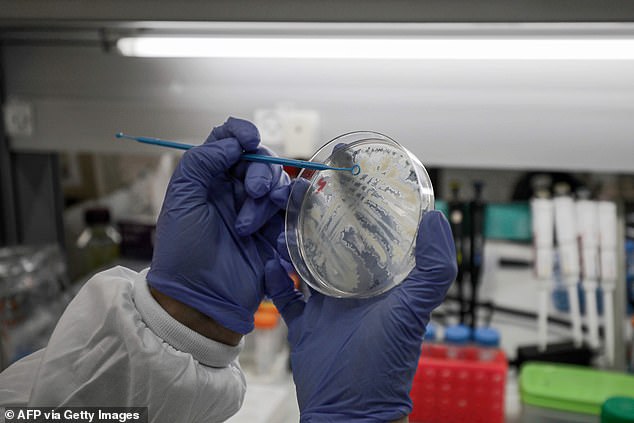

ចិនអះអាងថា វ៉ាក់សាំងប្រឆាំងនឹងវីរុស COVID-19 អាចនឹងប្រើប្រាស់ជាលើកដំបូងនៅខែក្រោយនេះហើយ

ចិន៖ យោងតាមសេចក្តីរាយការណ៍នៅក្នុងសារព័ត៌មាន Dailymail បានឲ្យដឹងថា ពេលនេះចិនបានរកឃើញវ៉ាក់សាំងប្រឆាំងនឹងវីរុស COVID-19 ហើយ ខណៈវ៉ាក់់សាំងដំបូងអាចនឹងដាក់ឲ្យប្រើប្រាស់នៅក្នុងដំណាក់កាលដំបូង ខែក្រោយនេះទៀតផង។ បើតាមលោក Zheng Zhongwe ដែលជានាយកមជ្ឈមណ្ឌលអភិវឌ្ឍន៍បច្ចេកទេសនិងស្រាវជ្រាវនៃគណៈកម្មការសុខភាពជាតិចិនបានឲ្យដឹងថា ក្នុងអំឡុងពេលនេះក្រុមអ្នកវិទ្យាសាស្រ្តចិនកំពុងតែដុតដៃដុតជើងយ៉ាងខ្លាំងក្នុងការអភិវឌ្ឍន៍ថ្នាំប្រឆាំងនឹងវីរុស COVID-19 ដោយពួកគេបានប្រើបច្ចេកវិទ្យាទំនើបៗ ៥ផ្សេងគ្នាក្នុងពេលតែមួយដើម្បីស្រាវជ្រាវនិងអភិវឌ្ឍន៍ថ្នាំជាច្រើនប្រភេទផងដែរ។
ជាងនេះទៅទៀតដំណើរការនៅក្នុងមន្ទីរពិសោធ៍ត្រូវធ្វើឡើងពេញ ២៤ ម៉ោង ដូចនេះក្រុមអ្នកវិទ្យាសាស្រ្តត្រូវប្តូរវេនគ្នាទៅសម្រាក ហើយអ្នកខ្លះវិញស្ទើរតែគ្មានពេលសម្រាកទៀតផង។ លោកបានបន្តថា COVID-19 ជាវីរុសថ្មីដែលគេត្រូវការពេលវេលាស្រាវជ្រាវ និងស្វែងយល់ពីវាជាជំហានៗទម្រាំតែគេអាចរកឃើញវិធីប្រឆាំងនឹងវាបាន។ លោក Zheng Zhongwe បានអះអាងថា ពេលនេះវ៉ាក់សាំងប្រឆាំងនឹងវីរុស COVID-19 ត្រូវបានធ្វើតេស្តិ៍វិជ្ជមានជាមួយនឹងសត្វហើយ ដោយឡែកការប្រើប្រាស់ចំពោះមនុស្សអាចនឹងកើតមានឡើងនៅក្នុងអំឡុងខែមេសាខាងមុខនេះ។ គួរបញ្ជាក់ជូនថា គិតមកទល់នឹងពេលនេះពិភពលោកទាំងមូលមានអ្នកឆ្លងវីរុស COVID-19 ចំនួន ១០២ ២២៤ ករណី ស្លាប់ ៣ ៤៩៥ ករណី និងព្យាបាលជាសះស្បើយចំនួន ៥៧ ៦១១ ករណី៕
អត្ថបទ៖ ភក្តី
ប្រភព៖ Dailymail